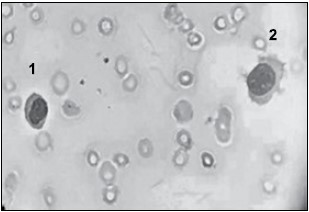
Enunciado 3519103-1

Foram encontradas 460 questões.
A contagem total de leucócitos no líquido cefalorraquidiano (LCR) representa o parâmetro mais sensível para caracterização de uma doença inflamatória do sistema nervoso central. Na contagem global de uma amostra de LCR de um adulto normal, pode-se visualizar:
Provas
Pessoas internadas em Unidades de Terapia Intensiva (UTI) estão mais suscetíveis a contrair infecções, devido ao uso de equipamentos invasivos que, como cateteres e respiradores para ventilação mecânica, que facilitam a entrada de bactérias e vírus. As espécies da família das enterobactérias são amplamente conhecidas por serem os principais patógenos relacionados a infecções associadas ao ambiente hospitalar (nosocomiais), sendo responsáveis por cerca de 50% dos casos de sepse.
Dentre as principais representantes da família Enterobacteriaceae, pode-se citar:
Provas
As infecções hospitalares ainda representam um grande desafio para a saúde pública em todo o mundo. Estas infecções, além de aumentarem o tempo de internação, podem também causar comorbidades graves e ainda levar ao óbito. Segundo a Agência Nacional de Vigilância Sanitária (ANVISA), nos últimos anos, o termo “infecções hospitalares” vem sendo substituído por um termo mais abrangente e preciso, que é:
Provas
O exame de hemograma demonstra os índices hematimétricos e nestes constam os parâmetros PDW e RDW, que indicam, respectivamente:
Provas
A febre maculosa é um tópico relevante em saúde pública. As estatísticas do último boletim epidemiológico publicado pelo Ministério da Saúde, compiladas pela BBC News Brasil, mostram que, entre 2012 e 2022, foram notificados 2 209 casos e 753 mortes por febre maculosa no país.
Sobre a febre maculosa, quando alcança o endotélio vascular e gera resposta inflamatória, é correto afirmar que há liberação de
Provas
Para determinar o diagnóstico de neoplasias intracelulares cervical vulvar e vaginal, como os carcinomas causadas pelo vírus Papilomavírus humano (HPV), tem-se como ferramenta a técnica de PCR em tempo real (qPCR) na Biologia molecular para complementar o diagnóstico. No exame, quando positivo, demonstra-se:
Provas
Paciente, masculino 39 anos, foi à Unidade de Pronto Atendimento no ABC Paulista, devido a equimoses nos membros inferiores e superiores. Relatou febre de 38 ºC por dois dias consecutivos e coceira intensa no corpo. O médico plantonista solicitou a realização de um hemograma. O laudo do hemograma demonstrou as seguintes concentrações de celularidades:
| HEMOGRAMA COMPLETO |
||||
| ERITROGRAMA |
VALOR DE REFERÊNCIA |
|||
| ERITRÓCITOS: |
3.85 milh/mm3 | 4,5 – 5,5 milh/mm3 |
||
| HEMOGLOBINA: |
8.2 g/dL | 13 – 17 g/dL |
||
| HEMATÓCRITO: |
25% |
40 – 50 % |
||
| VOLUME GLOBULAR MÉDIO: |
80 mcm3 |
80 – 100 mcm3 |
||
| HEMOGLOBINA GLOBULAR MÉDIA: |
27 pg | 27 – 32 pg |
||
| CONC. HEMOGLO. GLOB. MÉDIA: |
31.5 g/dL |
31,5 – 36 g/dL |
||
| RDW: |
17.2% |
12 – 15 % |
||
| OBSERVAÇÕES: |
||||
| LEUCOGRAMA |
||||
| % |
103/mm3 |
|||
| LEUCÓCITOS: |
3.6 103/mm3 | 4,5 – 11,0 |
||
| SEGMENTADOS: |
24.3 % |
4,81 103/mm3 | 50,0 – 80,0 |
2,00 – 8,00 |
| EOSINÓFILOS: |
1.0 % |
0.30 103/mm3 |
0 – 5,0 |
0 – 0,40 |
| BASÓFILOS: |
0.5 % |
0.04 103/mm3 |
0 – 2,0 |
0 – 0,20 |
| LINFÓCITOS: |
63.5 % |
1.84 103/mm3 |
25,0 – 50,0 |
1,00 – 5,00 |
| MONÓCITOS: |
6.7 % |
0.51 103/mm3 |
2,0 – 10,0 |
0,10 – 1,00 |
| LINFÓCITOS ATÍPICOS: |
0.0 % |
0.00 103/mm3 |
0 – 2,0 |
0 – 0,20 |
| MIELÓCITOS: |
0.0 % |
0.00 103/mm3 |
0 – 2,0 |
0 – 0,20 |
| METAMIELÓCITOS: |
0.0 % |
0.00 103/mm3 |
||
| BASTONETES: |
3.0 % |
0.08 103/mm3 |
||
| OBSERVAÇÕES: |
||||
| PLAQUETAS – CONTAGEM |
||||
| Plaquetas : |
24 103/mm3 |
|||
| VPM : |
11,4 mcm3 |
|||
| OBSERVAÇÕES: |
Foi realizado o esfregaço sanguíneo para confirmação do laudo. Assinale a alternativa que apresenta a descrição das células sinalizadas a seguir e a patologia a qual correspondem.
Figura 2
(Laudo e imagem cedidos pelo Laboratório de Análises Clínicas do Centro Universitário FMABC)
Provas
A coagulação intravascular disseminada (CIVD) é uma síndrome hemorrágica, na qual ocorre uma ativação anárquica dos fatores pró-coagulantes, plaquetas e de enzimas fibrinolíticas no espaço intravascular. O diagnóstico laboratorial da coagulação intravascular disseminada (CIVD) crônica consiste em:
Provas
Pacientes com covid-19 vêm sendo associados à Síndrome Antifosfolipide (SAF). Em relação a SAF, assinale a alternativa correta.
Provas
Foi solicitada uma curva de fragilidade osmótica a uma criança de 2 anos de idade, após a mãe descrever ao médico generalista a dificuldade de seu filho ter boa qualidade de vida devido às suas repetidas internações, quadros de infecções e anemia, sem sucesso após terapia com ferro. O esfregaço sanguíneo revelou poiquilocitose com presença de hemácias em alvo, hipocromia e anisocitose. Avaliando a curva de fragilidade osmótica, sugere-se um quadro de:
Figura 1

Figura 2

(Laudo e imagem cedidos pelo Laboratório de Análises Clínicas do Centro Universitário FMABC)
Provas
Caderno Container